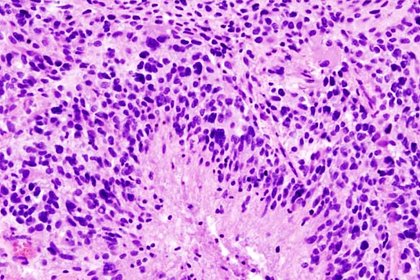

Исследователи из Канады установили, что люди могут защитить себя от смертельно опасного вируса COVID-19 при помощи нового вида конопли. В рамках эксперимента ученые проверили, как экстракт Cannabis sativa будут взаимодействовать с вирусом. »
В Канаде перекупщик PlayStation 5 подрался за консоль с грабителями
Во время разговора один из грабителей брызнул в продавца из перцового баллончика и пытался убежать с консолью, но перекупщик его остановил. Последовавшая за этим драка была заснята автомобильным регистратором Несмотря на то что грабителей было трое, отобрать PS5 они не смогли. »
В Канаде в перестрелке между полицией и преступником погиб ребенок
Преступник обезврежен, обстоятельства произошедшего выясняются. Один человек погиб, два получили ранения в результате стрельбы с участием полиции в канадской провинции Онтарио, сообщает ТАСС со ссылкой на телеканал СBC. Инцидент произошел в 135 километрах от Торонто в городке Каварта-Лэйкс. »
Exxon Mobil объявила о сокращении сотрудников в Канаде
Exxon Mobil планирует до конца 2021 года уволить до 300 сотрудников своих филиалов в Канаде, говорится в компании. Сокращения коснутся работников подразделений Imperial Oil Limited, ExxonMobil Canada Ltd. и ExxonMobil Business Centre Canada ULC. »
В разломе асфальта на улице в Торонто прохожие заметили светящуюся зеленую слизь
Странную, будто радиоактивную слизь обнаружили жители Торонто 20 ноября в разломе асфальта на Гастингс-авеню. Об этом сообщает 680NEWS. Точно такая же слизь участвовала в превращении обычных черепашек в Черепашек-ниндзя. »
Создатель Dragon Age основал новую студию под названием Yellow Brick Games
Квебек, Канада, 24 ноября 2020, 15:25 — REGNUM Автор серии игр Dragon Age Майк Лэйдлоу объявил об основании своей собственной студии по разработке видеоигр. Она будет называться Yellow Brick Games, сообщило издание Eurogamer 23 ноября. »
Автор Dragon Age открыл новую студию с ветеранами BioWare и Ubisoft — Yellow Brick Games
Творческий руководитель серии Dragon Age Майк Лейдлоу объявил об учреждении собственной игровой студии в Квебеке — Yellow Brick Games. Сейчас в студии уже работают ветераны BioWare, Electronic Arts и Ubisoft, которые трудились над Mass Effect, Dragon Age, Assassin's Creed и Watch Dogs. »
Вор украл пустой кассовый аппарат и провалился с ним в ледяную реку
Залез в закрытый магазин, долго ковырялся с кассой, не смог вскрыть и понес ее с собой. »
Британия и Канада на G20 подписали новое торговое соглашение из-за Brexit
П20Правительства Канады и Великобритании подписали соглашение о свободной торговле. Об этом 21 ноября заявил канадский премьер-министр Джастин Трюдо в ходе видеообращения на саммите G20. Новое торговое соглашение стало заменой ранее заключенного договора о торговле между ЕС и Канадой. »
Учёные из Канады обнаружили генетический источник молодости
Некоторые франко-канадские семьи обладают изменёнными генными структурами, обеспечивающими долголетие. Исследователи изучили редкую генетическую мутацию в нескольких семьях, представители которых имеют канадские и французские корни. Учёные изучили их гены и заявили, что открыли источник молодости. »
Канадский доктор разбил все меры борьбы с COVID: «Люди ходят, повинуясь, как лемминги»
Ни социальная дистанция, ни маски ни от чего не спасут. Социальное дистанцирование бесполезно, потому что коронавирус распространяется аэрозолями, которые пролетают за 30 метров, маски, в которых "люди ходят, повинуясь, как лемминги", совершенно бесполезны. »
Канада пока не дает разрешение на полеты Boeing 737 MAX
Власти Канады пока не дают разрешение на возобновление коммерческих полетов самолетов Boeing 737 MAX в своем воздушном пространстве, но процесс восстановления допуска на их эксплуатацию уже запущен. Об этом в среду говорится в заявлении главы канадского Минтранса Марка Гарно. »
Кошка привела котят знакомиться со спасшей ее от голода женщиной
Почувствовавшая себя настоящей хозяйкой животного женщина разволновалась – но в один из дней кошка все-таки вернулась, и не одна. Она появилась в компании шестерых котят, которым хотела показать свою спасительницу в надежде, что та прокормит и ее детей. »
В Канаде создали аппарат, который позволяет быстрее трезветь
Ученые из Канады разработали помогающее протрезветь устройство, которое уже получило название «Машина трезвости», сообщает телеканал CBC. С виду изобретение похоже на бокс, который соединен с дыхательной маской шлангом. »
Глубокое и быстрое дыхание помогает очистить организм от алкоголя
Эксперты предлагают задействовать в данном процессе легкие. Ученые выяснили, что при гипервентиляции, то есть глубоком и быстром дыхании, выведение алкоголя осуществляется в 3 раза быстрее, чем печенью. Как они утверждают, сила дыхания влияет на количество выведенного алкоголя из организма. »
В Канаде защитники природы решили купить остров за $1,7 млн
Канадский фонд защиты дикой природы BC Parks решил собрать $1,7 млн на покупку острова Западный Балленас, который богат редкими видами растений. Об этом 14 ноября сообщает CNN. Деньги фонду надо собрать до 17 ноября. »
В Канаде искусственному интеллекту рекомендовали уважать права человека
Оттава, 13 ноября 2020, 17:58 — REGNUM 12 ноября 2020 года канадское Управление уполномоченного по вопросам конфиденциальности (OPC) опубликовало рекомендации по регулированию искусственного интеллекта (ИИ) в Канаде, в которых оно призывает к принятию законодательства, предусматривающему поправки в Закон о защите личной информации и электронных...подробнее »
Ученые обнаружили способ быстрой очистки организма от алкоголя
Ученые из Канады рассказали, как гипервентиляция легких может помочь легко и быстро очистить организм от алкоголя. »
В Торонто ссору в «Макдональдсе» решил топор
Один из зачинщиков драки зашел обратно в ресторан, второй ушел. В скором времени выяснилось, что ненадолго. Достав из багажника своего автомобиля топор, мужчина вернулся за дальнейшими приключениями. »
Кулинарный мастер-класс по изготовлению пончиков провели в «Берегине»
Виртуальное занятие «Пончики» состоялось в Семейном центре «Берегиня». В процессе эфира зрители не только опробовали один из рецептов, но и узнали способы приготовления блюда в других странах. »
Ректором бизнес-школы Сколково станет профессор из Канады Юрий Левин
Профессор канадской Школы бизнеса Стивена Смита (Smith School of Business) Юрий Левин, специалист в области бизнес-аналитики и искусственного интеллекта, станет ректором Московской школы управления Сколково (бизнес-школы Сколково), сообщили в понедельник в пресс-службе МШУ Сколково. »
Рейтинги канадских университетов 2018

Университет Макгилла (McGill University) занял 42-ое место в рейтинге лучших высших учебных заведений мирового значения журнала Times Higher Education на 2018 год и 32 местo – в академическом рейтинге британской консалтинговой компании Quacquarelli Symonds – QS World University Rankings – 2018. Рейтинг лучших университетов мира QS World University Rankings оценивает университеты по следующим показателям:...подробнее »
Pейтинг квебекских школ, 2017 (Institut Fraser)

Ежегодный рейтинг средних школ Квебека (частных и государственных, английских и французских) “Bulletin des écoles secondaires du Québec 2017” проводился институтом Fraser и был опубликован 12 ноября 2017 года в газете “Journal de Montréal” : “Le Palmarès des écoles secondaires du Journal de Montréal”. 57 учебных заведений, показавших существенный прогресс в рейтинге 2017 Карта, которая позволит...подробнее »
Рейтинг государственных начальных школ Mонреаля от LaPresse 2015

LaPresse составила свой рейтинг 2015 года четырехсот французских государственных начальных школ (primaire) из шести школьных комиссий Большого Монреаля, исходя из результатов министерских экзаменов по французскому языку и математике выпускных шестых классов. Рейтинг состоит из трех частей, в которых школы сгруппированы по социально-экономическому принципу: I. Школы из благополучных районов с высоким доходом: Rang Nom de...подробнее »
Канада: Успеваемость детей-иммигрантов различается по провинциям

В среду 18 ноября 2015 года статистическое управление Канады (Statistique Canada) обнародовало результаты своего исследования, сравнивающее академические успехи по чтению и математике детей-иммигрантов со своими сверстниками – канадцами третьего поколения (чьи родители родились в Канаде) в различных провинциях страны. Исследование базировалось на предоставленных PEI (Programme d’éducation Internationale) результатax успеваемости 15-летних канадских школьников за период с...подробнее »
Рейтинг квебекских школ (secondaires) 2014 года MELS

Mинистерство Образования Квебека MELS (Ministere de l’Education, du Loisir et du Sport du Quebec) 23 мая 2014 года опубликовало на своeм сайте результаты единого провинциального теста и рейтинг всех средних школ Квебека (частных и государственных, английских и французских) по результатам министерских экзаменов. В июне 2013 года 143 465 учащихся из четвертого и пятого секондера...подробнее »
Монреаль: куда пойти учиться?

Выбор школы (secondaire) В октябре месяце в Монреале наступает горячая пора сдачи вступительных экзаменов в secondaire (перехода из начальной школы в среднюю). В течение двух-трех недель толпы родителей с детьми кочуют из одного колледжа в другой. У каждого свой подход к выбору: кто-то рассматривает только частные престижные колледжи с высоким рейтингом, кто-то ищет подходящую...подробнее »
Что мы едим в Канаде?

Каждый из нас, “русских канадцев”, волею судеб, либо осуществляя свой сознательный выбор, очутившийся в этой далекой от России стране хоккея и кленового сиропа, стране, считающейся одной из “лучших стран мира”, стране с “высоким уровнем жизни, медицинского обеспечения и образования” и так далее, как полагается по рекламным туристическим буклетам, старается приспособиться к жизни в этой...подробнее »
Проблемы детей иммиграции

В настоящее время в высокоразвитых странах (США, Германии, Израиле, Италии, Канаде, Франции) проживают около 5 миллионов российских по происхождению детей. При этом ни в одной стране нет служб психологической поддержки ни для этих детей, ни для их родителей. Их и не могло быть, поскольку проблему психологической адаптации на “новой родине” пока никто не изучал....подробнее »
Интересные места

Восстановленная ирокезская деревня середины XV века Музей университета McGill Redpath Museum Туристический комплекс – Старый порт Центр науки и техники в Старом порту Водный Комплекс на острове Св. Елены Биодом / Biodôme de Montréal Каток в подземном городе “Atrium Le 1000” Монреальский планетарий Insectarium de Montréal Канадский музей железнодорожного транспорта Экомузей Ботанический сад Oratoire...подробнее »
Потерянная Империя

Фотографии Сергея Михайловича Прокудина–Горского (1863-1944) предлагают живой портрет потерянного мира – Российской Империи накануне Первой мировой войны и надвигающейся революции. Сюда входят изображения от средневековых церквей и монастырей старой России до железных дорог и фабрик растущей промышленной державы и повседневной жизни и работы разнообразного населения России. Сергей Михайлович Прокудин-Горский (1863-1944) впервые объявил о создании...подробнее »
Cохранениe русского языка в Канаде

“Особенности функционирования русского языка в Канаде: проблемы сохранения и преподавания” Русская Канада – это многонациональное сообщество, говорящее, в большинстве своем, в своей среде на русском языке. Одним из основных тезисов современной лингвистики является утверждение языковой системы как пластичной, адаптивной к языковому окружению, коим являются социальная и культурная сферы, его использующие. Другими словами, языковая система...подробнее »
Начальные спец. школы Монреаля

Школа с артистическим уклоном F.A.C.E Детские школы Монтессори в Монреале Школа с уклоном в естественные науки Fernand-Seguin École internationale de Montréal Школа с музыкальным уклоном Le Plateau Монреальский хор мальчиков Высшая школа современного балета в Монреале (ESBCM) Осторожно! Вальдорфская школа в Монреале »